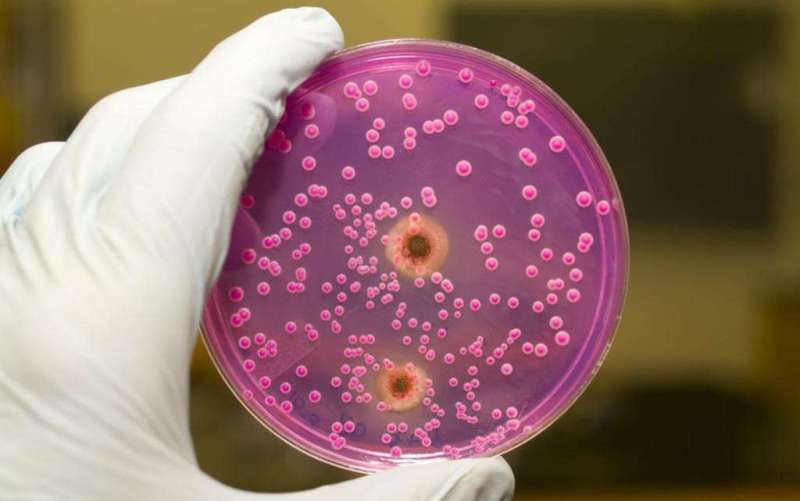
Проблемы в лечении инвазивных грибковых инфекций при трансплантации стволовых клеток (Transplant Infectious Disease, октябрь 2023)

Профессиональный аккаунт
У вас пока нет действующего кабинета в МИС "МедЭлемент". Создать кабинет частной практики?
Обзоры мировой медицинской периодики. Новые материалы о стандартах диагностики и лечения заболеваний. Клинические протоколы, клинические рекомендации. Медицинская платформа МедЭлемент